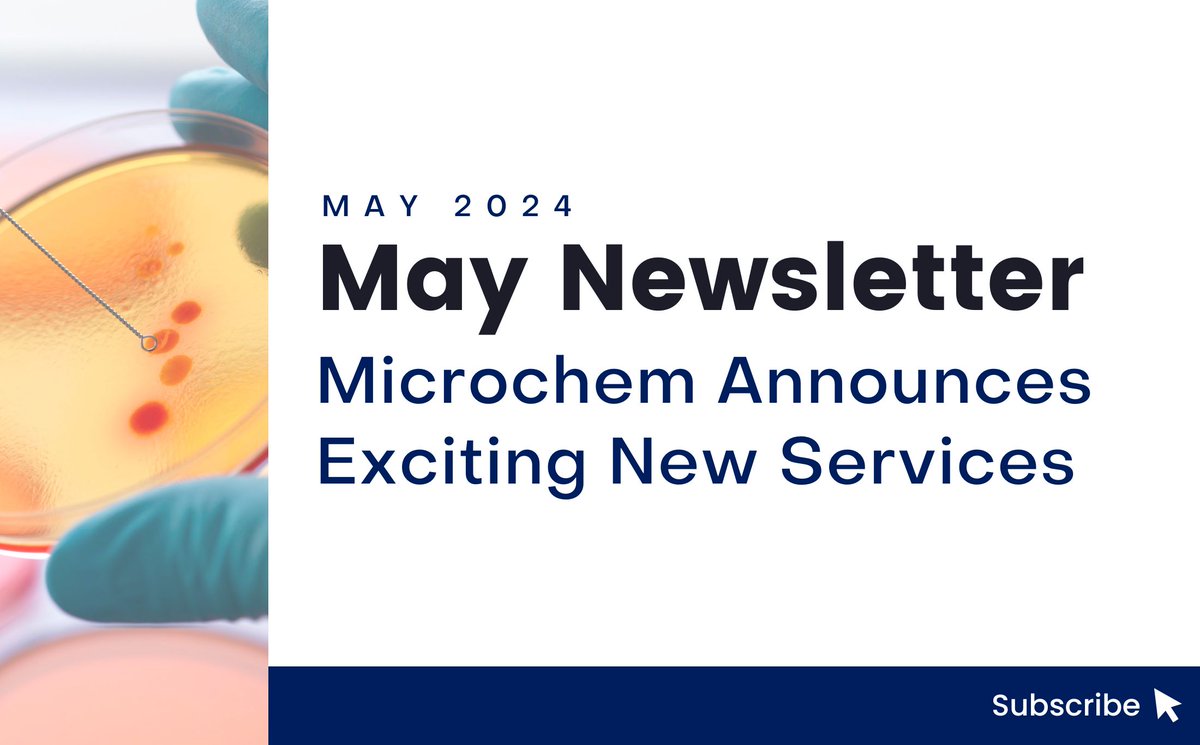
Microchem is announcing exciting new services this month! Sign up for our newsletter to be the first to know.

microchemlab.us3.list-manage.com/subscribe?u=40…

Microchem Laboratory
@microchemlab
Microchem Laboratory provides fast, accurate product testing of antimicrobials, disinfectants, medical devices, and cosmetics.
ID: 3193581787
http://microchemlab.com 12-05-2015 18:19:03
126 Tweet
122 Takipçi
43 Takip Edilen





Amazing! On our last day, Microchem Laboratory comes in with a HUGE order to get us very close to our goal! They just ordered 50 LAB COATS, which puts us over 500 and within striking distance. Please repost saying thank you for being our biggest supporter so far, and take a look at